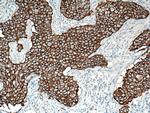
HER2/ErbB2 Antibody in Immunohistochemistry (Paraffin) (IHC (P))

Search
Proteintech
HER2/ErbB2 Monoclonal Antibody (1B12A7)
{{$productOrderCtrl.translations['antibody.pdp.commerceCard.promotion.promotions']}}
{{$productOrderCtrl.translations['antibody.pdp.commerceCard.promotion.viewpromo']}}
{{$productOrderCtrl.translations['antibody.pdp.commerceCard.promotion.promocode']}}: {{promo.promoCode}} {{promo.promoTitle}} {{promo.promoDescription}}. {{$productOrderCtrl.translations['antibody.pdp.commerceCard.promotion.learnmore']}}
产品信息
60311-1-IG
种属反应
已发表种属
宿主/亚型
分类
类型
克隆号
抗原
偶联物
形式
浓度
规格
纯化类型
保存液
内含物
保存条件
运输条件
产品详细信息
Immunogen sequence: TQVCTGTDM KLRLPASPET HLDMLRHLYQ GCQVVQGNLE LTYLPTNASL SFLQDIQEVQ GYVLIAHNQV RQVPLQRLRI VRGTQLFEDN YALAVLDNGD PLNNTTPVTG ASPGGLRELQ LRSLTEILKG GVLIQRNPQL CYQDTILWKD IFHKNNQLAL TLIDTNRSRA CHPCSPMCKG SRCWGESSED CQSLTRTVCA GGCARCKGPL PTDCCHEQCA AGCTGPKHSD CLACLHFNHS GICELHCPAL VTYNTDTFES MPNPEGRYTF GASCVTACPY NYLSTDVGSC TLVCPLHNQE VTAEDGTQRC EKCSKPCARV CYGLGMEHLR EVRAVTSANI QEFAGCKKIF G (23-372 aa encoded by BC156755)
靶标信息
ErbB2 (HER2) is a receptor tyrosine kinase that is overexpressed in some breast tumors. Herceptin, used in treatment of metastatic Her2-positive cancer, is monoclonal antibody targeting this kinase.
仅用于科研。不用于诊断过程。未经明确授权不得转售。
生物信息学
蛋白别名: approximately 68 kDa secreted autoinhibitor glycoprotein; c-erb B2/neu protein; CD antigen CD340; CD340; erb-b2; erbb 2; ErbB2 (pTyr1139); ErbB2 (pY1139); ErbB2 phospho Y1139; her 2; HER2 receptor; HER2/neu receptor; herstatin; human epidermal growth factor receptor 2; metas; Metastatic lymph node gene 19 protein; MLN 19; neuro/glioblastoma derived oncogene homolog; neuroblastoma/glioblastoma derived oncogene homolog; p185erbB2; phospho ErbB2; Proto-oncogene c-ErbB-2; Proto-oncogene Neu; Receptor tyrosine-protein kinase erbB-2; Tyrosine kinase-type cell surface receptor HER2; unnamed protein product; v-erb-b2 avian erythroblastic leukemia viral oncogene homolog 2; v-erb-b2 avian erythroblastic leukemia viral oncoprotein 2; v-erb-b2 erythroblastic leukemia viral oncogene homolog 2, neuro/glioblastoma derived oncogene homolog
基因别名: c-ERB-2; c-ERB2; CD340; ERBB2; HER-2; HER-2/neu; HER2; MLN 19; MLN-19; MLN19; NEU; NGL; p185(erbB2); TKR1; VSCN2
UniProt ID: (Human) P04626
Entrez Gene ID: (Human) 2064